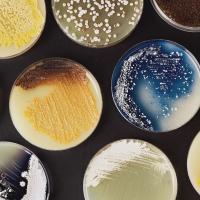
Synthetic biology

Batteries don’t last forever, including rechargeable ones. When batteries finally die, they need to be recycled. However, because so many different technologies rely on them, we currently need to recycle about 500,000 tons of batteries every year.
When batteries are recycled, they are shredded and melted — and literally turned back into their constituent atomic elements. The batteries are then rebuilt, essentially from scratch.
A company called ReCell is trying to improve this process with a method called “direct recycling,” which maintains the structural integrity of a part of the battery called the cathode. This should make battery recycling more energy efficient and environmentally friendly.